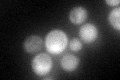
YMR220W
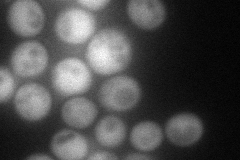
YMR220W
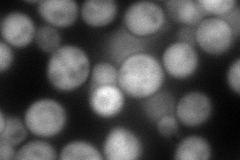
YMR220W
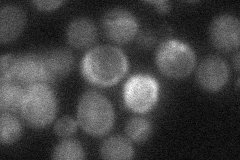
YMR220W
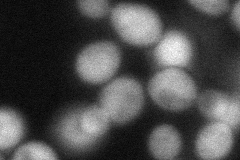
YMR220W
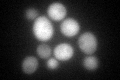
YMR220W
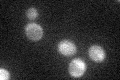
YMR220W

View description
Phosphomevalonate kinase, an essential cytosolic enzyme that acts in the biosynthesis of isoprenoids and sterols, including ergosterol, from mevalonate
Localization:
Intensity:
Fold change:
Significance:
-
C’ GFP library in SD
cytosol54.73 -
N' NOP1pr-GFP in SD
cytosol88.9505 -
N' TEF2pr-mCherry in SD
cytosol150.534 -
N' NATIVEpr-GFP in SD
cytosol21.7276 -
N' TEF2pr-VC and Cyto-VN in SD
cytosol65.3877 -
C’ GFP library in SD+DTT
cytosol53.330.97No -
C’ GFP library in SD+H2O2

cytosol45.460.83No -
C’ GFP library in Starvation Media
cytosol39.250.71No -
C’ GFP library on the background of Pup2-DaMP

cytosol -
C’ GFP library on the background of CCT mutant

cytosol49.92740.912165No
